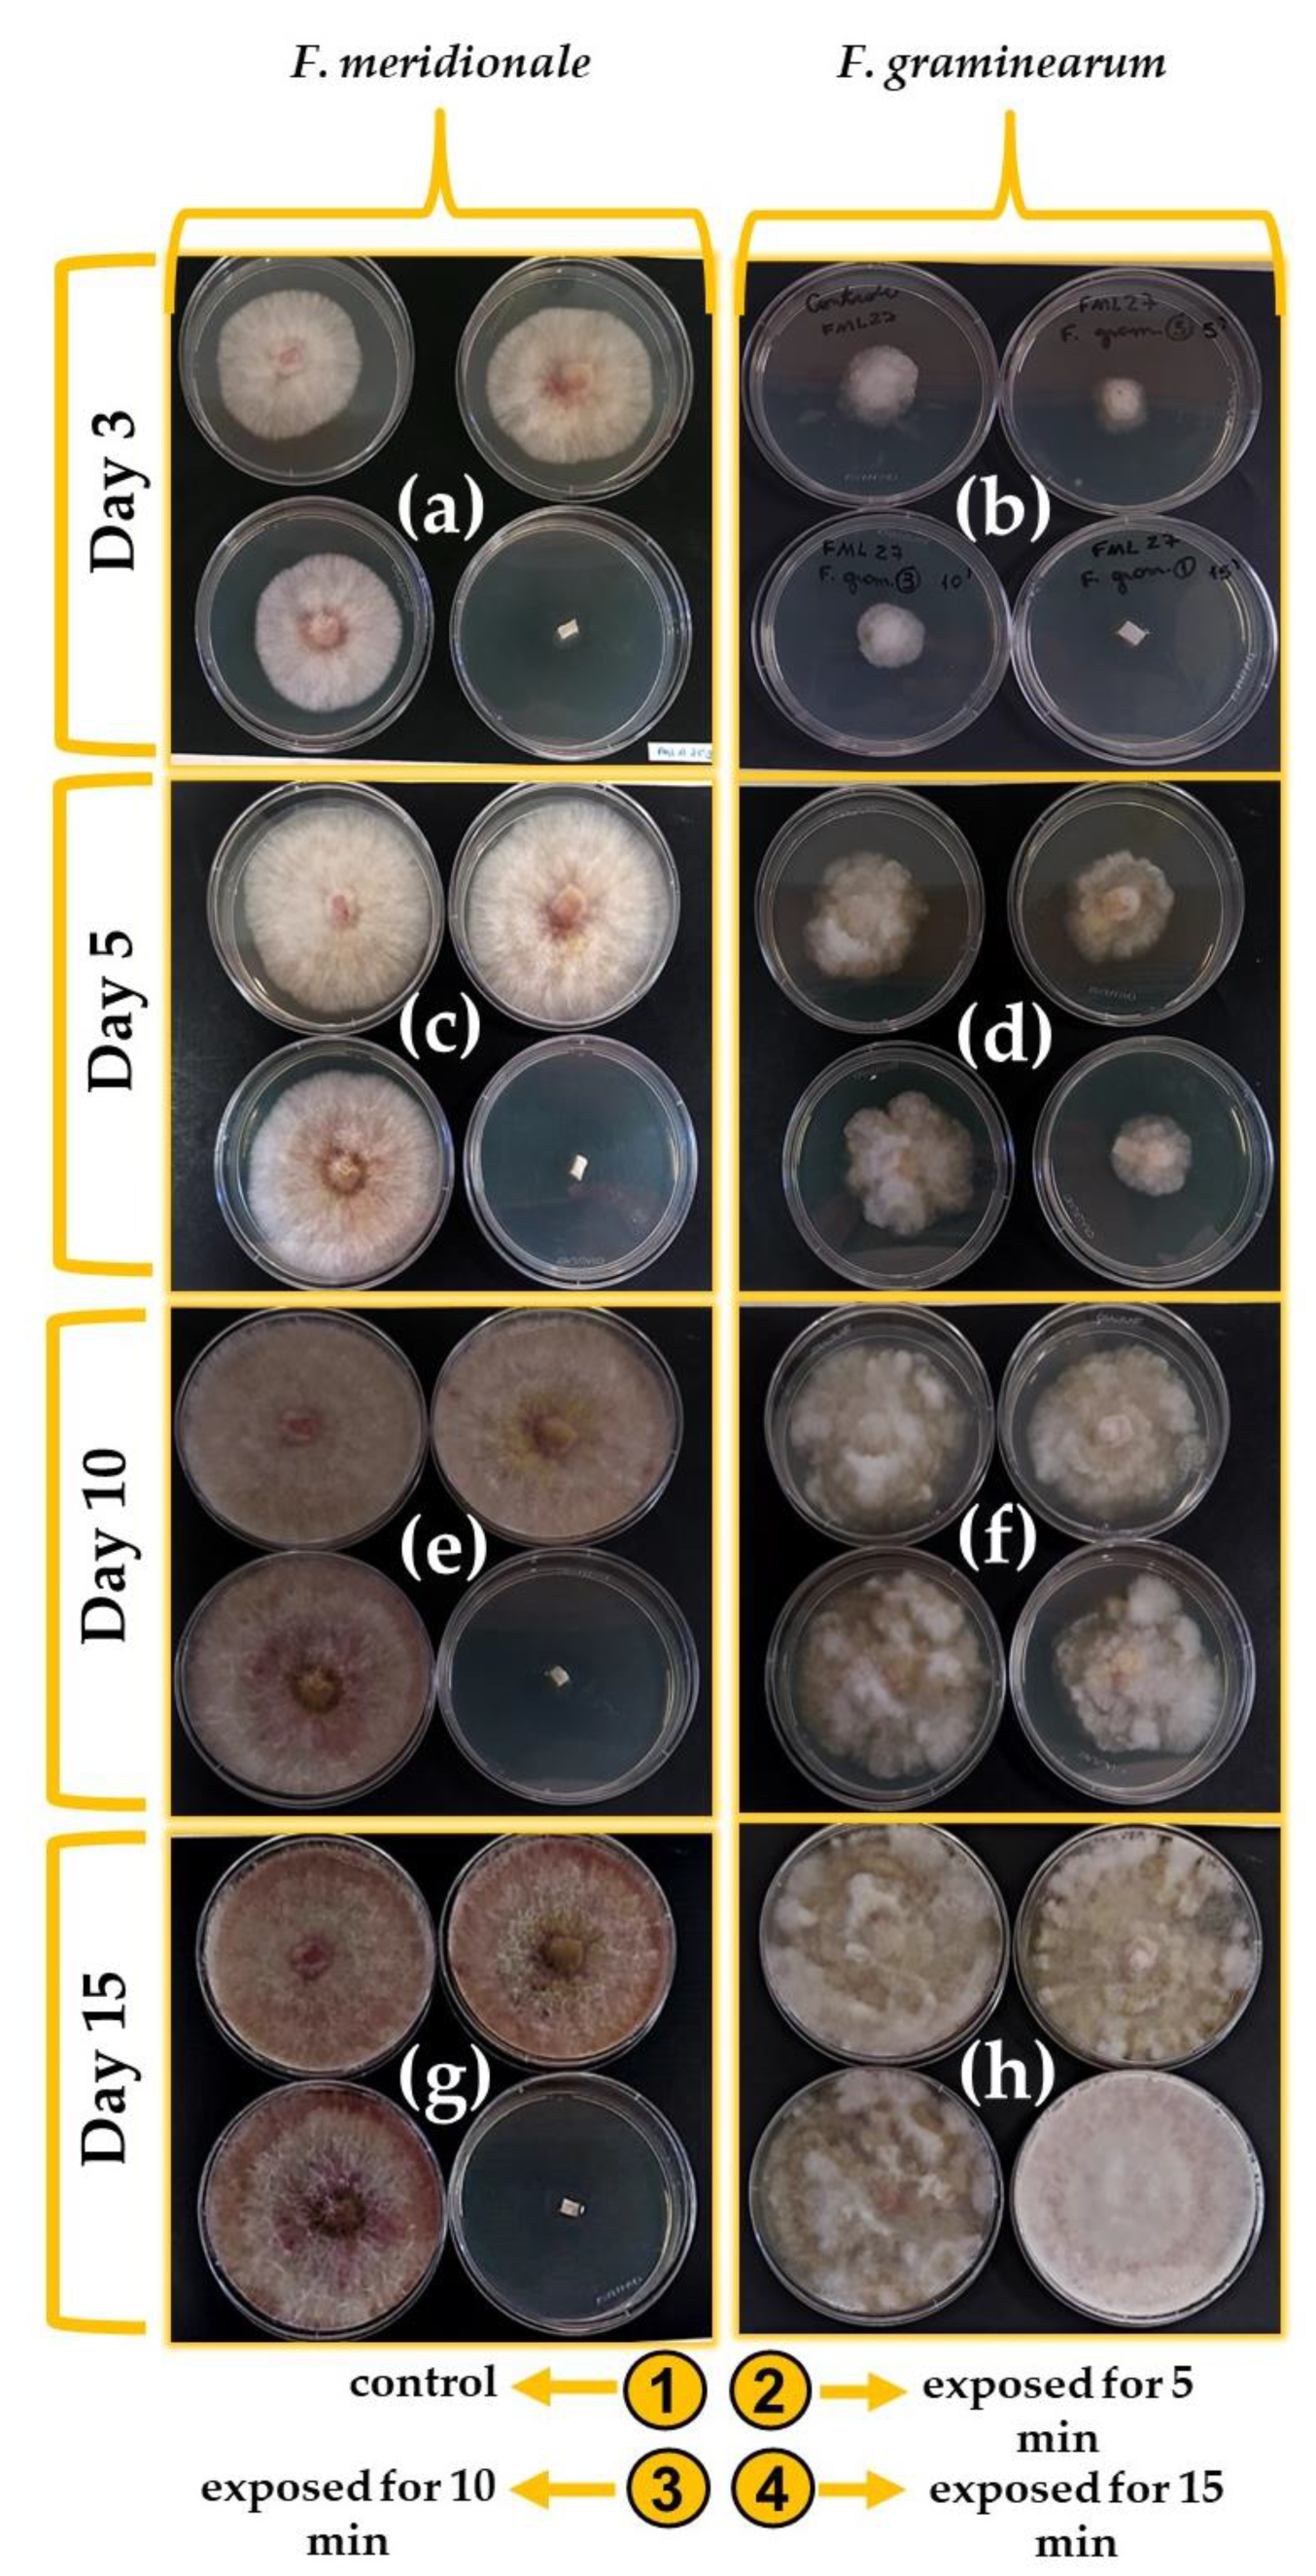
Ijerph 20 05072 g004

Effect of Gliding Arc Plasma Jet on the Mycobiota and Deoxynivalenol Levels in Naturally Contaminated Barley Grains
Abstract
1. Introduction
2. Materials and Methods
2.1. Strains of the Fusarium graminearum Species Complex
2.1.1. Effect of Gliding Arc Plasma Jet on F. graminearum and F. meridionale
2.1.2. Effect of Gliding Arc Plasma Jet on Cell Viability of F. graminearum and F. meridionale
2.2. Barley Grains Treated by Gliding Arc Plasma Jet
2.2.1. Mycobiota of Barley Grains
2.2.2. Analysis of Deoxynivalenol and Deoxynivalenol-3 Glucoside
2.3. Statistical Analysis of Data
3. Results and Discussion
3.1. Effect of Gliding Arc Plasma Jet on F. graminearum and F. meridionale Strains
Effect of Gliding Arc Plasma Jet on Cell Viability of F. graminearum and F. meridionale
3.2. Effect of Gliding Arc Plasma Jet on the Mycobiota of Barley Grains
3.3. Effect of Gliding Arc Plasma Jet on Deoxynivalenol and Deoxynivalenol-3-Glucoside
4. Conclusions
Author Contributions
Funding
Institutional Review Board Statement
Informed Consent Statement
Data Availability Statement
Acknowledgments
Conflicts of Interest
References
- Fridman, G.; Brooks, A.D.; Balasubramanian, M.; Fridman, A.; Gutsol, A.; Vasilets, V.N.; Ayan, H.; Friedman, G. Comparison of Direct and Indirect Effects of Non-Thermal Atmospheric-Pressure Plasma on Bacteria. Plasma Process. Polym. 2007, 4, 370–375. [Google Scholar] [CrossRef]
- Milhan, N.V.M.; Chiappim, W.; Sampaio, A.d.G.; da Cruz Vegian, M.R.; Pessoa, R.S.; Koga-ito, C.Y. Applications of Plasma-Activated Water in Dentistry: A Review. Int. J. Mol. Sci. 2022, 23, 4131. [Google Scholar] [CrossRef] [PubMed]
- Oh, J.S.; Szili, E.J.; Gaur, N.; Hong, S.H.; Furuta, H.; Kurita, H.; Mizuno, A.; Hatta, A.; Short, R.D. How to Assess the Plasma Delivery of RONS into Tissue Fluid and Tissue. J. Phys. D Appl. Phys. 2016, 49, 304005. [Google Scholar] [CrossRef]
- Liu, Z.; Zhou, C.; Liu, D.; He, T.; Guo, L.; Xu, D.; Kong, M.G. Quantifying the Concentration and Penetration Depth of Long-Lived RONS in Plasma-Activated Water by UV Absorption Spectroscopy. AIP Adv. 2019, 9, 015014. [Google Scholar] [CrossRef]
- Liu, Z.; Gao, Y.; Liu, D.; Pang, B.; Wang, S.; Zhou, C.; Zhang, H.; Xu, D.; Kong, M.G. Dynamic Analysis of Absorbance Behavior and Peak Shift of RONS in Plasma-Activated Water by UV Absorption Spectroscopy: Dependency on Gas Impurity, Pulse Polarity, and Solution PH. J. Phys. D Appl. Phys. 2021, 54, 015202. [Google Scholar] [CrossRef]
- Lima, G.d.M.G.; Borges, A.C.; Nishime, T.M.C.; Santana-Melo, G.d.F.; Kostov, K.G.; Mayer, M.P.A.; Koga-Ito, C.Y. Cold Atmospheric Plasma Jet as a Possible Adjuvant Therapy for Periodontal Disease. Molecules 2021, 26, 5590. [Google Scholar] [CrossRef]
- Nascimento, F.; Petroski, K.; Kostov, K. Effects of O2 Addition on the Discharge Parameters and Production of Reactive Species of a Transferred Atmospheric Pressure Plasma Jet. Appl. Sci. 2021, 11, 6311. [Google Scholar] [CrossRef]
- Leite, L.D.P.; de Oliveira, M.A.C.; Vegian, M.R.d.C.; Sampaio, A.d.G.; Nishime, T.M.C.; Kostov, K.G.; Koga-Ito, C.Y. Effect of Cold Atmospheric Plasma Jet Associated to Polyene Antifungals on Candida Albicans Biofilms. Molecules 2021, 26, 5815. [Google Scholar] [CrossRef]
- Chiappim, W.; Sampaio, A.; Miranda, F.; Petraconi, G.; da Silva Sobrinho, A.; Cardoso, P.; Kostov, K.; Koga-Ito, C.; Pessoa, R. Nebulized Plasma-Activated Water Has an Effective Antimicrobial Effect on Medically Relevant Microbial Species and Maintains Its Physicochemical Properties in Tube Lengths from 0.1 up to 1.0 m. Plasma Process. Polym. 2021, 18, 2100010. [Google Scholar] [CrossRef]
- Szili, E.J.; Oh, J.S.; Hong, S.H.; Hatta, A.; Short, R.D. Probing the Transport of Plasma-Generated RONS in an Agarose Target as Surrogate for Real Tissue: Dependency on Time, Distance and Material Composition. J. Phys. D Appl. Phys. 2015, 48, 202001. [Google Scholar] [CrossRef]
- Kutasi, K.; Popović, D.; Krstulović, N.; Milošević, S. Tuning the Composition of Plasma-Activated Water by a Surface-Wave Microwave Discharge and a KHz Plasma Jet. Plasma Sources Sci. Technol. 2019, 28, 095010. [Google Scholar] [CrossRef]
- Doria, A.C.O.C.; Figueira, F.R.; de Lima, J.S.B.; Figueira, J.A.N.; Castro, A.H.R.; Sismanoglu, B.N.; Petraconi, G.; Maciel, H.S.; Khouri, S.; Pessoa, R.S. Inactivation of Candida Albicans Biofilms by Atmospheric Gliding Arc Plasma Jet: Effect of Gas Chemistry/Flow and Plasma Pulsing. Plasma Res. Express 2019, 1, 015001. [Google Scholar] [CrossRef]
- van Gils, C.A.J.; Hofmann, S.; Boekema, B.K.H.L.; Brandenburg, R.; Bruggeman, P.J. Mechanisms of Bacterial Inactivation in the Liquid Phase Induced by a Remote RF Cold Atmospheric Pressure Plasma Jet. J. Phys. D Appl. Phys. 2013, 46, 175203. [Google Scholar] [CrossRef]
- Chiappim, W.; Sampaio, A.d.G.; Miranda, F.; Fraga, M.; Petraconi, G.; da Silva Sobrinho, A.; Kostov, K.; Koga-Ito, C.; Pessoa, R. Antimicrobial Effect of Plasma-Activated Tap Water on Staphylococcus Aureus, Escherichia Coli, and Candida Albicans. Water 2021, 13, 1480. [Google Scholar] [CrossRef]
- Mercado-Cabrera, A.; Peña-Eguiluz, R.; LÓpez-Callejas, R.; Jaramillo-Sierra, B.; Valencia-Alvarado, R.; Rodríguez-Méndez, B.; Muñoz-Castro, A.E. Novel Electrode Structure in a DBD Reactor Applied to the Degradation of Phenol in Aqueous Solution. Plasma Sci. Technol. 2017, 19, 075501. [Google Scholar] [CrossRef]
- Laroussi, M.; Akan, T. Arc-Free Atmospheric Pressure Cold Plasma Jets: A Review. Plasma Process. Polym. 2007, 4, 777–788. [Google Scholar] [CrossRef]
- Oh, J.S.; Szili, E.J.; Hatta, A.; Ito, M.; Shirafuji, T. Tailoring the Chemistry of Plasma-Activated Water Using a DC-Pulse-Driven Non-Thermal Atmospheric-Pressure Helium Plasma Jet. Plasma 2019, 2, 127–137. [Google Scholar] [CrossRef]
- Lu, X.; Laroussi, M.; Puech, V. On Atmospheric-Pressure Non-Equilibrium Plasma Jets and Plasma Bullets. Plasma Sources Sci. Technol. 2012, 21, 034005. [Google Scholar] [CrossRef]
- Burlica, R.; Kirkpatrick, M.J.; Locke, B.R. Formation of Reactive Species in Gliding Arc Discharges with Liquid Water. J. Electrostat. 2006, 64, 35–43. [Google Scholar] [CrossRef]
- Wartel, M.; Faubert, F.; Dirlau, I.D.; Rudz, S.; Pellerin, N.; Astanei, D.; Burlica, R.; Hnatiuc, B.; Pellerin, S. Analysis of Plasma Activated Water by Gliding Arc at Atmospheric Pressure: Effect of the Chemical Composition of Water on the Activation. J. Appl. Phys. 2021, 129, 233301. [Google Scholar] [CrossRef]
- Sampaio, A.d.G.; Chiappim, W.; Milhan, N.V.M.; Botan Neto, B.; Pessoa, R.; Koga-Ito, C.Y. Effect of the PH on the Antibacterial Potential and Cytotoxicity of Different Plasma-Activated Liquids. Int. J. Mol. Sci. 2022, 23, 3893. [Google Scholar] [CrossRef]
- Xu, D.; Wang, S.; Li, B.; Qi, M.; Feng, R.; Li, Q.; Zhang, H.; Chen, H.; Kong, M.G. Effects of Plasma-Activated Water on Skin Wound Healing in Mice. Microorganisms 2020, 8, 1091. [Google Scholar] [CrossRef] [PubMed]
- Adil, B.H.; Al-Shammari, A.M.; Murbat, H.H. Breast Cancer Treatment Using Cold Atmospheric Plasma Generated by the FE-DBD Scheme. Clin. Plasma Med. 2020, 19–20, 100103. [Google Scholar] [CrossRef]
- Erfani, R.; Carmichael, C.; Sofokleous, T.; Wang, Q. Nanosecond-Pulsed DBD Plasma Treatment on Human Leukaemia Jurkat Cells and Monoblastic U937 Cells in Vitro. Sci. Rep. 2022, 12, 6270. [Google Scholar] [CrossRef] [PubMed]
- Bekeschus, S.; Kramer, A.; Schmidt, A. Gas Plasma-Augmented Wound Healing in Animal Models and Veterinary Medicine. Molecules 2021, 26, 5682. [Google Scholar] [CrossRef]
- Giraldo, P.; Benavente, E.; Manzano-Agugliaro, F.; Gimenez, E. Worldwide Research Trends on Wheat and Barley: A Bibliometric Comparative Analysis. Agronomy 2019, 9, 352. [Google Scholar] [CrossRef]
- Mohapatra, D.; Kumar, S.; Kotwaliwale, N.; Singh, K.K. Critical Factors Responsible for Fungi Growth in Stored Food Grains and Non-Chemical Approaches for Their Control. Ind. Crops Prod. 2017, 108, 162–182. [Google Scholar] [CrossRef]
- Bolechová, M.; Benešová, K.; Běláková, S.; Čáslavský, J.; Pospíchalová, M.; Mikulíková, R. Determination of Seventeen Mycotoxins in Barley and Malt in the Czech Republic. Food Control. 2015, 47, 108–113. [Google Scholar] [CrossRef]
- Piacentini, K.C.; Rocha, L.O.; Savi, G.D.; Carnielli-Queiroz, L.; Almeida, F.G.; Minella, E.; Corrêa, B. Occurrence of Deoxynivalenol and Zearalenone in Brewing Barley Grains from Brazil. Mycotoxin Res. 2018, 34, 173–178. [Google Scholar] [CrossRef]
- Pereira, C.B.; Ward, T.J.; del Ponte, E.M.; Moreira, G.M.; Busman, M.; McCormick, S.P.; Feksa, H.R.; de Almeida, J.L.; Tessmann, D.J. Five-Year Survey Uncovers Extensive Diversity and Temporal Fluctuations among Fusarium Head Blight Pathogens of Wheat and Barley in Brazil. Plant Pathol. 2020, 70, 426–435. [Google Scholar] [CrossRef]
- Machado, F.J.; Nicolli, C.P.; Möller, P.A.; Arruda, R.; Ward, T.J.; del Ponte, E.M. Differential Triazole Sensitivity among Members of the Fusarium Graminearum Species Complex Infecting Barley Grains in Brazil. Trop. Plant Pathol. 2017, 42, 197–202. [Google Scholar] [CrossRef]
- da SILVA, J.V.B.; de OLIVEIRA, C.A.F.; Ramalho, L.N.Z. An Overview of Mycotoxins, Their Pathogenic Effects, Foods Where They Are Found and Their Diagnostic Biomarkers. Food Sci. Technol. 2022, 42, 1–9. [Google Scholar] [CrossRef]
- Bullerman, L.B.; Bianchini, A. Stability of Mycotoxins during Food Processing. Int. J. Food Microbiol. 2007, 119, 140–146. [Google Scholar] [CrossRef]
- Chen, D.; Chen, P.; Cheng, Y.; Peng, P.; Liu, J.; Ma, Y.; Liu, Y.; Ruan, R. Deoxynivalenol Decontamination in Raw and Germinating Barley Treated by Plasma-Activated Water and Intense Pulsed Light. Food Bioproc. Tech. 2019, 12, 246–254. [Google Scholar] [CrossRef]
- Huang, Y.; Haas, M.; Heinen, S.; Steffenson, B.J.; Smith, K.P.; Muehlbauer, G.J. Qtl Mapping of Fusarium Head Blight and Correlated Agromorphological Traits in an Elite Barley Cultivar Rasmusson. Front. Plant Sci. 2018, 9, 1260. [Google Scholar] [CrossRef]
- Dahl, B.; Wilson, W.W. Risk Premiums Due to Fusarium Head Blight (FHB) in Wheat and Barley. Agric. Syst. 2018, 162, 145–153. [Google Scholar] [CrossRef]
- Foroud, N.A.; Baines, D.; Gagkaeva, T.Y.; Thakor, N.; Badea, A.; Steiner, B.; Bürstmayr, M.; Bürstmayr, H. Trichothecenes in Cereal Grains-An Update. Toxins 2019, 11, 634. [Google Scholar] [CrossRef]
- Varga, E.; Malachova, A.; Schwartz, H.; Krska, R.; Berthiller, F. Survey of Deoxynivalenol and Its Conjugates Deoxynivalenol-3-Glucoside and 3-Acetyl-Deoxynivalenol in 374 Beer Samples. Food Addit. Contam.-Part A 2013, 30, 137–146. [Google Scholar] [CrossRef]
- Lemos, A.C.; Borba, V.S.d.; Badiale-Furlong, E. The Impact of Wheat-Based Food Processing on the Level of Trichothecenes and Their Modified Forms. Trends Food Sci. Technol. 2021, 111, 89–99. [Google Scholar] [CrossRef]
- Suman, M. Fate of Free and Modified Forms of Mycotoxins during Food Processing. Toxins 2020, 12, 448. [Google Scholar] [CrossRef]
- Braghini, R.; Sucupira, M.; Rocha, L.O.; Reis, T.A.; Aquino, S.; Corrêa, B. Effects of Gamma Radiation on the Growth of Alternaria Alternata and on the Production of Alternariol and Alternariol Monomethyl Ether in Sunflower Seeds. Food Microbiol. 2009, 26, 927–931. [Google Scholar] [CrossRef] [PubMed]
- Purar, B.; Djalovic, I.; Bekavac, G.; Grahovac, N.; Krstović, S.; Latković, D.; Janić Hajnal, E.; Živančev, D. Changes in Fusarium and Aspergillus Mycotoxin Content and Fatty Acid Composition after the Application of Ozone in Different Maize Hybrids. Foods 2022, 11, 2877. [Google Scholar] [CrossRef] [PubMed]
- Wang, J.; Ogata, M.; Hirai, H.; Kawagishi, H. Detoxification of Aflatoxin B1 by Manganese Peroxidase from the White-Rot Fungus Phanerochaete Sordida YK-624. FEMS Microbiol. Lett. 2011, 314, 164–169. [Google Scholar] [CrossRef] [PubMed]
- Abd-Elsalam, K.A.; Vasil’kov, A.Y.; Said-Galiev, E.E.; Rubina, M.S.; Khokhlov, A.R.; Naumkin, A.v.; Shtykova, E.v.; Alghuthaymi, M.A. Bimetallic Blends and Chitosan Nanocomposites: Novel Antifungal Agents against Cotton Seedling Damping-Off. Eur. J. Plant Pathol. 2018, 151, 57–72. [Google Scholar] [CrossRef]
- Sarangapani, C.; Patange, A.; Bourke, P.; Keener, K.; Cullen, P.J. Recent Advances in the Application of Cold Plasma Technology in Foods. Annu. Rev. Food Sci. Technol. 2018, 9, 609–629. [Google Scholar] [CrossRef]
- Karlovsky, P.; Suman, M.; Berthiller, F.; de Meester, J.; Eisenbrand, G.; Perrin, I.; Oswald, I.P.; Speijers, G.; Chiodini, A.; Recker, T.; et al. Impact of Food Processing and Detoxification Treatments on Mycotoxin Contamination. Mycotoxin Res. 2016, 32, 179–205. [Google Scholar] [CrossRef]
- Misra, N.N.; Yadav, B.; Roopesh, M.S.; Jo, C. Cold Plasma for Effective Fungal and Mycotoxin Control in Foods: Mechanisms, Inactivation Effects, and Applications. Compr. Rev. Food Sci. Food Saf. 2019, 18, 106–120. [Google Scholar] [CrossRef]
- Wang, X.; Wang, S.; Yan, Y.; Wang, W.; Zhang, L.; Zong, W. The Degradation of Alternaria Mycotoxins by Dielectric Barrier Discharge Cold Plasma. Food Control. 2020, 117, 107333. [Google Scholar] [CrossRef]
- ten Bosch, L.; Pfohl, K.; Avramidis, G.; Wieneke, S.; Viöl, W.; Karlovsky, P. Plasma-Based Degradation of Mycotoxins Produced by Fusarium, Aspergillus and Alternaria Species. Toxins 2017, 9, 97. [Google Scholar] [CrossRef]
- Gavahian, M.; Cullen, P.J. Cold Plasma as an Emerging Technique for Mycotoxin-Free Food: Efficacy, Mechanisms, and Trends. Food Rev. Int. 2020, 36, 193–214. [Google Scholar] [CrossRef]
- Iwase, C.H.T.; Piacentini, K.C.; Giomo, P.P.; Čumová, M.; Wawroszová, S.; Běláková, S.; Minella, E.; Rocha, L.O. Characterization of the Fusarium Sambucinum Species Complex and Detection of Multiple Mycotoxins in Brazilian Barley Samples. Food Res. Int. 2020, 136, 109336. [Google Scholar] [CrossRef]
- Tralamazza, S.M.; Bemvenuti, R.H.; Zorzete, P.; de Souza Garcia, F.; Corrêa, B. Fungal Diversity and Natural Occurrence of Deoxynivalenol and Zearalenone in Freshly Harvested Wheat Grains from Brazil. Food Chem. 2016, 196, 445–450. [Google Scholar] [CrossRef]
- Piacentini, K.C.; Savi, G.D.; Pereira, M.E.V.; Scussel, V.M. Fungi and the Natural Occurrence of Deoxynivalenol and Fumonisins in Malting Barley (Hordeum vulgare L.). Food Chem. 2015, 187, 204–209. [Google Scholar] [CrossRef]
- Pinheiro, M.; Iwase, C.H.T.; Bertozzi, B.G.; Caramês, E.T.S.; Carnielli-Queiroz, L.; Langaro, N.C.; Furlong, E.B.; Correa, B.; Rocha, L.O. Survey of Freshly Harvested Oat Grains from Southern Brazil Reveals High Incidence of Type b Trichothecenes and Associated Fusarium Species. Toxins 2021, 13, 855. [Google Scholar] [CrossRef]
- Phan, K.T.K.; Phan, H.T.; Brennan, C.S.; Regenstein, J.M.; Jantanasakulwong, K.; Boonyawan, D.; Phimolsiripol, Y. Gliding Arc Discharge Non-Thermal Plasma for Retardation of Mango Anthracnose. LWT 2019, 105, 142–148. [Google Scholar] [CrossRef]
- Patriarca, A.; Vaamonde, G.; Fernandez Pinto, V.; Comerió, R. Influence of Water Activity and Temperature on the Growth of Wallemia Sebi: Application of a Predictive Model. Int. J. Food Microbiol. 2001, 68, 61–67. [Google Scholar] [CrossRef]
- Braschi, G.; Patrignani, F.; Siroli, L.; Lanciotti, R.; Schlueter, O.; Froehling, A. Flow Cytometric Assessment of the Morphological and Physiological Changes of Listeria Monocytogenesand Escherichia Coliin Response to Natural Antimicrobial Exposure. Front. Microbiol. 2018, 9, 2783. [Google Scholar] [CrossRef]
- Rocha, L.O.; Tralamazza, S.M.; Reis, G.M.; Rabinovitch, L.; Barbosa, C.B.; Corrêa, B. Multi-Method Approach for Characterizing the Interaction between Fusarium Verticillioides and Bacillus Thuringiensis Subsp. Kurstaki. PLoS ONE 2014, 9, e92189. [Google Scholar] [CrossRef]
- Pitt, T.L.; Barer, M.R. Chapter 3-Classification, Identification and Typing of Micro-Organisms Medical Microbiology. In Medical Microbiology; Greenwood, D., Barer, M., Slack, R., Irving, W., Eds.; Churchill Livisgtone: Edinburgh, UK, 2012; Volume 1, pp. 24–38. [Google Scholar]
- Rosa Seus Arraché, E.; Fontes, M.R.V.; Garda Buffon, J.; Badiale-Furlong, E. Trichothecenes in Wheat: Methodology, Occurrence and Human Exposure Risk. J. Cereal Sci. 2018, 82, 129–137. [Google Scholar] [CrossRef]
- Los, A.; Ziuzina, D.; Bourke, P. Current and Future Technologies for Microbiological Decontamination of Cereal Grains. J. Food Sci. 2018, 83, 1484–1493. [Google Scholar] [CrossRef]
- Selcuk, M.; Oksuz, L.; Basaran, P. Decontamination of Grains and Legumes Infected with Aspergillus Spp. and Penicillum spp. by Cold Plasma Treatment. Bioresour. Technol. 2008, 99, 5104–5109. [Google Scholar] [CrossRef] [PubMed]
- Ikehata, H.; Ono, T. The Mechanisms of UV Mutagenesis. J. Radiat. Res. 2011, 52, 115–125. [Google Scholar] [CrossRef] [PubMed]
- Guo, J.; Wang, J.; Xie, H.; Jiang, J.; Li, C.; Li, W.; Li, L.; Liu, X.; Lin, F. Inactivation Effects of Plasma-Activated Water on Fusarium Graminearum. Food Control. 2022, 134, 108683. [Google Scholar] [CrossRef]
- Pawłat, J.; Terebun, P.; Kwiatkowski, M.; Tarabová, B.; Kovaľová, Z.; Kučerová, K.; Machala, Z.; Janda, M.; Hensel, K. Evaluation of Oxidative Species in Gaseous and Liquid Phase Generated by Mini-Gliding Arc Discharge. Plasma Chem. Plasma Process. 2019, 39, 627–642. [Google Scholar] [CrossRef]
- Patil, B.S.; Rovira Palau, J.; Hessel, V.; Lang, J.; Wang, Q. Plasma Nitrogen Oxides Synthesis in a Milli-Scale Gliding Arc Reactor: Investigating the Electrical and Process Parameters. Plasma Chem. Plasma Process. 2016, 36, 241–257. [Google Scholar] [CrossRef]
- Zhu, L.; Gunn, C.; Beckman’, J.S. Bactericidal Activity of Peroxynitrite. Arch. Biochem. 1992, 298, 452–457. [Google Scholar] [CrossRef] [PubMed]
- Zhou, R.; Zhou, R.; Prasad, K.; Fang, Z.; Speight, R.; Bazaka, K.; Ostrikov, K. Cold Atmospheric Plasma Activated Water as a Prospective Disinfectant: The Crucial Role of Peroxynitrite. Green Chem. 2018, 20, 5276–5284. [Google Scholar] [CrossRef]
- Laurita, R.; Barbieri, D.; Gherardi, M.; Colombo, V.; Lukes, P. Chemical Analysis of Reactive Species and Antimicrobial Activity of Water Treated by Nanosecond Pulsed DBD Air Plasma. Clin. Plasma Med. 2015, 3, 53–61. [Google Scholar] [CrossRef]
- Walkowiak, S.; Rowland, O.; Rodrigue, N.; Subramaniam, R. Whole Genome Sequencing and Comparative Genomics of Closely Related Fusarium Head Blight Fungi: Fusarium Graminearum, F. Meridionale and F. Asiaticum. BMC Genom. 2016, 17, 1014. [Google Scholar] [CrossRef]
- Kang, M.H.; Pengkit, A.; Choi, K.; Jeon, S.S.; Choi, H.W.; Shin, D.B.; Choi, E.H.; Uhm, H.S.; Park, G. Differential Inactivation of Fungal Spores in Water and on Seeds by Ozone and Arc Discharge Plasma. PLoS ONE 2015, 10, e0139263. [Google Scholar] [CrossRef]
- Šimončicová, J.; Kaliňáková, B.; Kováčik, D.; Medvecká, V.; Lakatoš, B.; Kryštofová, S.; Hoppanová, L.; Palušková, V.; Hudecová, D.; Ďurina, P.; et al. Cold Plasma Treatment Triggers Antioxidative Defense System and Induces Changes in Hyphal Surface and Subcellular Structures of Aspergillus Flavus. Appl. Microbiol. Biotechnol. 2018, 102, 6647–6658. [Google Scholar] [CrossRef]
- Masiello, M.; Somma, S.; lo Porto, C.; Palumbo, F.; Favia, P.; Fracassi, F.; Logrieco, A.F.; Moretti, A. Plasma Technology Increases the Efficacy of Prothioconazole against Fusarium Graminearum and Fusarium Proliferatum Contamination of Maize (Zea Mays) Seedlings. Int. J. Mol. Sci. 2021, 22, 9301. [Google Scholar] [CrossRef]
- Zahoranová, A.; Hoppanová, L.; Šimončicová, J.; Tučeková, Z.; Medvecká, V.; Hudecová, D.; Kaliňáková, B.; Kováčik, D.; Černák, M. Effect of Cold Atmospheric Pressure Plasma on Maize Seeds: Enhancement of Seedlings Growth and Surface Microorganisms Inactivation. Plasma Chem. Plasma Process. 2018, 38, 969–988. [Google Scholar] [CrossRef]
- Kordas, L.; Pusz, W.; Czapka, T.; Kacprzyk, R. The Effect of Low-Temperature Plasma on Fungus Colonization of Winter Wheat Grain and Seed Quality. Pol. J. Environ. Stud. 2015, 24, 433–438. [Google Scholar]
- Freire, L.; Sant’Ana, A.S. Modified Mycotoxins: An Updated Review on Their Formation, Detection, Occurrence, and Toxic Effects. Food Chem. Toxicol. 2018, 111, 189–205. [Google Scholar] [CrossRef]
- Maul, R.; Müller, C.; Rieß, S.; Koch, M.; Methner, F.J.; Irene, N. Germination Induces the Glucosylation of the Fusarium Mycotoxin Deoxynivalenol in Various Grains. Food Chem. 2012, 131, 274–279. [Google Scholar] [CrossRef]
- Lancova, K.; Hajslova, J.; Poustka, J.; Krplova, A.; Zachariasova, M.; Dostalek, P.; Sachambula, L. Transfer of Fusarium Mycotoxins and ‘Masked’ Deoxynivalenol (Deoxynivalenol-3-Glucoside) from Field Barley through Malt to Beer. Food Addit. Contam. Part A Chem. Anal. Control Expo. Risk Assess. 2008, 25, 732–744. [Google Scholar] [CrossRef]
- Havelka, Z.; Běláková, S.; Bohatá, A.; Hartman, I.; Kábelová, H.; Kříž, P.; Benešová, K.; Dienstbier, M.; Bartoš, P.; Špatenka, P. The Effect of Low-Temperature Plasma Discharge on Mycotoxin Content in Barley and Malt. Kvas. Prum. 2019, 65. [Google Scholar] [CrossRef]
- Kříž, P.; Petr, B.; Zbyněk, H.; Jaromír, K.; Pavel, O.; Petr, Š.; Miroslav, D. Influence of Plasma Treatment in Open Air on Mycotoxin Content and Grain Nutriments. Plasma Med. 2015, 5, 145–158. [Google Scholar] [CrossRef]

| GAPJ Parameters | Values |
|---|---|
| discharge power (W) | 8.5 |
| frequency (kHz) | 19.2 |
| peak-to-peak current (mA) | 2.4 |
| peak-to-peak voltage (kV) | 3.5 |
| compressed air flow (L/min) | 5 |
| nozzle distance (cm) | 0.5 |
| Time of Exposure to GAPJ | Yeasts (Log UFC/g) | Alternaria spp. (Log UFC/g) | FGSC ** (Log UFC/g) | Aspergillus spp. (Log UFC/g) |
|---|---|---|---|---|
| 0 min * | 5.90 d *** | 3.38 g | 2.85 j | 1.08 l |
| 10 min | 5.61 d | 2.32 h | 2.85 j | 0.54 m |
| 20 min | 4.73 e | 1.88 i | 1.67 k | 0.62 m |
| 30 min | 3.26 f | 1.53 i | 1.75 k | 0.52 m |
| Samples | Samples Not Treated by GAPJ | Samples Treated by GAPJ for 20 min | ∆(DON (%) | ||
|---|---|---|---|---|---|
| DON (µg/Kg) | D3G (µg/Kg) | DON (µg/Kg) | D3G (µg/Kg) | ||
| 1 | 828.4 | 35 | 258 | 930 | −69 |
| 2 | 554.8 | 20 | 600 | 1050 | +8 |
| 3 | 261.1 | 15 | 332 | 800 | +27 |
| 4 | 1293.6 | 15 | 373 | 460 | −71 |
| 5 | 1836.2 | <LOD * | 409 | 1090 | −78 |
| 6 | 2131.1 | <LOD | 404 | 1090 | −81 |
| 7 | 897.8 | <LOD | 400 | 2450 | −55 |
| 8 | 1174.6 | LOD | 450 | 570 | −62 |
| 9 | 873.2 | 15 | 292 | 510 | −67 |
| 10 | 2074.4 | <LOD | 230 | 1980 | −89 |
| 11 | 1732.7 | <LOD | 460 | 930 | −73 |
| 12 | 1572 | 39 | 380 | 840 | −76 |
| 13 | 880.3 | 22 | 870 | 420 | −1 |
| 14 | 674.5 | 21 | 690 | 400 | +2 |
| 15 | 1062.9 | 32.1 | 520 | 300 | −51 |
| 16 | 1945.2 | <LOD | 660 | 1110 | −66 |
| 17 | 1897 | 84.1 | 464 | 300 | −76 |
| 18 | 554 | 15 | 740 | 350 | +34 |
| 19 | 871.1 | 15 | 595 | 810 | −32 |
| 20 | 1240.6 | <LOD | 222 | 850 | −82 |
Disclaimer/Publisher’s Note: The statements, opinions and data contained in all publications are solely those of the individual author(s) and contributor(s) and not of MDPI and/or the editor(s). MDPI and/or the editor(s) disclaim responsibility for any injury to people or property resulting from any ideas, methods, instructions or products referred to in the content. |
© 2023 by the authors. Licensee MDPI, Basel, Switzerland. This article is an open access article distributed under the terms and conditions of the Creative Commons Attribution (CC BY) license (https://creativecommons.org/licenses/by/4.0/).
Share and Cite
Chiappim, W.; de Paula Bernardes, V.; Almeida, N.A.; Pereira, V.L.; Bragotto, A.P.A.; Cerqueira, M.B.R.; Furlong, E.B.; Pessoa, R.; Rocha, L.O. Effect of Gliding Arc Plasma Jet on the Mycobiota and Deoxynivalenol Levels in Naturally Contaminated Barley Grains. Int. J. Environ. Res. Public Health 2023, 20, 5072. https://doi.org/10.3390/ijerph20065072
Chiappim W, de Paula Bernardes V, Almeida NA, Pereira VL, Bragotto APA, Cerqueira MBR, Furlong EB, Pessoa R, Rocha LO. Effect of Gliding Arc Plasma Jet on the Mycobiota and Deoxynivalenol Levels in Naturally Contaminated Barley Grains. International Journal of Environmental Research and Public Health. 2023; 20(6):5072. https://doi.org/10.3390/ijerph20065072
Chicago/Turabian StyleChiappim, William, Vanessa de Paula Bernardes, Naara Aparecida Almeida, Viviane Lopes Pereira, Adriana Pavesi Arisseto Bragotto, Maristela Barnes Rodrigues Cerqueira, Eliana Badiale Furlong, Rodrigo Pessoa, and Liliana Oliveira Rocha. 2023. "Effect of Gliding Arc Plasma Jet on the Mycobiota and Deoxynivalenol Levels in Naturally Contaminated Barley Grains" International Journal of Environmental Research and Public Health 20, no. 6: 5072. https://doi.org/10.3390/ijerph20065072
APA StyleChiappim, W., de Paula Bernardes, V., Almeida, N. A., Pereira, V. L., Bragotto, A. P. A., Cerqueira, M. B. R., Furlong, E. B., Pessoa, R., & Rocha, L. O. (2023). Effect of Gliding Arc Plasma Jet on the Mycobiota and Deoxynivalenol Levels in Naturally Contaminated Barley Grains. International Journal of Environmental Research and Public Health, 20(6), 5072. https://doi.org/10.3390/ijerph20065072

